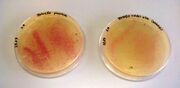
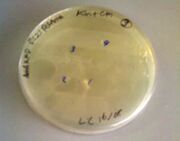

Uploads by Lucy Clark
From OpenWetWare
Jump to navigationJump to search
This special page shows all uploaded files.
| Date | Name | Thumbnail | Size | Description |
|---|---|---|---|---|
| 13:07, 19 September 2013 | BIORAD 2013-09-18 16hr 02min 2.JPG (file) |  |
15 KB | |
| 12:58, 19 September 2013 | BIORAD 2013-09-18 16hr 02min.JPG (file) |  |
16 KB | |
| 13:52, 18 September 2013 | BIORAD 2013-09-06 16hr 21min.JPG (file) |  |
16 KB | |
| 13:51, 18 September 2013 | BIORAD 2013-09-06 14hr 13min.jpg (file) |  |
104 KB | |
| 12:05, 29 August 2013 | 994568 157275804469334 23825595 n.jpg (file) |  |
128 KB | |
| 14:43, 22 August 2013 | WP 000051.jpg (file) | |
48 KB | |
| 14:14, 22 August 2013 | BIORAD 2013-08-22 14hr 32min.JPG (file) |  |
16 KB | |
| 14:05, 22 August 2013 | BIORAD 2013-08-21 15hr 47min.JPG (file) |  |
18 KB | |
| 13:19, 21 August 2013 | Bl21 Anta + Rfp.jpg (file) | |
17 KB | |
| 12:54, 21 August 2013 | Bl21 Anta plates.jpg (file) |  |
23 KB | |
| 12:05, 21 August 2013 | 30 july.JPG (file) |  |
29 KB | |
| 11:05, 21 August 2013 | BL21 plates 16-08.JPG (file) | 23 KB | ||
| 09:16, 15 August 2013 | BIORAD 2013-08-09 16hr 23min.jpg (file) |  |
17 KB | |
| 09:06, 15 August 2013 | BIORAD 2013-08-09 16hr 21min.jpg (file) |  |
17 KB | |
| 10:56, 9 August 2013 | 08-08 etbr stain gel.JPG (file) |  |
10 KB | |
| 11:32, 7 August 2013 | 31-07.JPG (file) |  |
26 KB | |
| 14:32, 31 July 2013 | BIORAD 2013-07-25 15hr 59min.JPG (file) |  |
18 KB | |
| 14:06, 31 July 2013 | BIORAD 2013-07-23 16hr 38min.JPG (file) |  |
22 KB | |
| 13:45, 31 July 2013 | 2013-07-11 cut sites confirmation.jpg (file) |  |
22 KB | |
| 12:10, 31 July 2013 | 156px-9-7-2013 (2).jpg (file) |  |
16 KB | |
| 12:04, 31 July 2013 | 347px-27-6-2013 (2).jpg (file) |  |
33 KB | |
| 11:40, 31 July 2013 | 800px-21 june.jpg (file) |  |
20 KB | |
| 11:38, 31 July 2013 | 800px-26 june.jpg (file) |  |
15 KB | |
| 11:35, 31 July 2013 | 21 june.jpg (file) |  |
20 KB | |
| 11:29, 31 July 2013 | Restriction digestion 1 edit.JPG (file) |  |
23 KB | |
| 20:31, 26 July 2013 | Ben thompson visit.jpg (file) |  |
76 KB | |
| 08:46, 25 July 2013 | Sds page jpeg.JPG (file) |  |
21 KB | |
| 13:17, 19 July 2013 | Meet up.jpg (file) |  |
158 KB | |
| 11:51, 8 July 2013 | Eurogentec(preliminary).png (file) |  |
76 KB | |
| 14:58, 20 June 2013 | Restriction digestion 1(preliminary).png (file) |  |
15 KB | |
| 13:20, 12 June 2013 | Logo(preliminary).png (file) |  |
41 KB | |
| 09:45, 12 June 2013 | (preliminary).png (file) |  |
54 KB | |
| 18:55, 8 June 2013 | Squiggle 2(preliminary).png (file) |  |
60 KB |